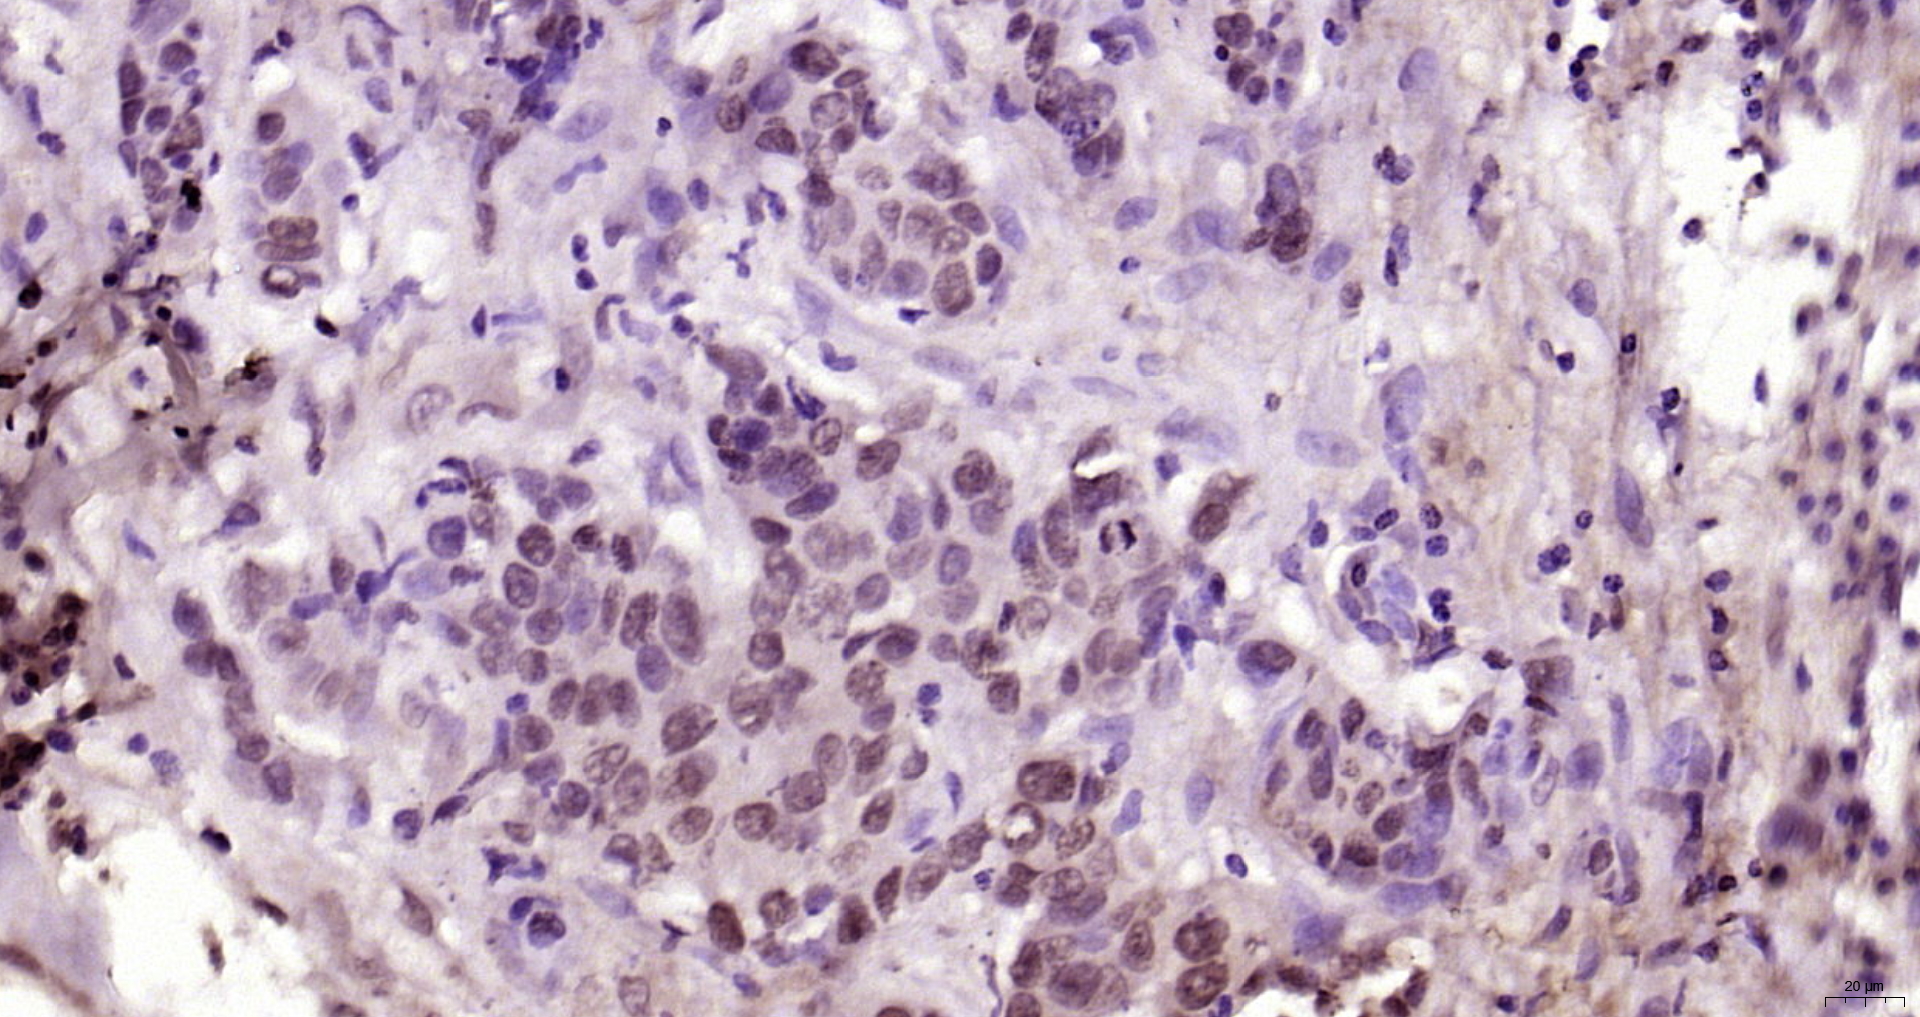

Lane 1: NIH/3T3 cell lysates probed with YAP1(Tyr407) Polyclonal Antibody, Unconjugated (bs-3476R) at 1:1000 dilution and 4˚C overnight incubation. Followed by conjugated secondary antibody incubation at 1:20000 for 60 min at 37˚C.
Phospho-YAP1 (Tyr407) Polyclonal Antibody
BS-3476R
ApplicationsImmunoFluorescence, Western Blot, ELISA, ImmunoCytoChemistry, ImmunoHistoChemistry, ImmunoHistoChemistry Frozen, ImmunoHistoChemistry Paraffin
Product group Antibodies
ReactivityBovine, Canine, Chicken, Equine, Human, Mouse, Porcine, Rabbit, Rat
TargetYAP1
Overview
- SupplierBioss
- Product NamePhospho-YAP1 (Tyr407) Polyclonal Antibody
- Delivery Days Customer16
- ApplicationsImmunoFluorescence, Western Blot, ELISA, ImmunoCytoChemistry, ImmunoHistoChemistry, ImmunoHistoChemistry Frozen, ImmunoHistoChemistry Paraffin
- Applications SupplierWB(1:300-5000), ELISA(1:500-1000), IHC-P(1:200-400), IHC-F(1:100-500), IF(IHC-P)(1:50-200), IF(IHC-F)(1:50-200), IF(ICC)(1:50-200)
- CertificationResearch Use Only
- ClonalityPolyclonal
- Concentration1 ug/ul
- ConjugateUnconjugated
- Gene ID10413
- Target nameYAP1
- Target descriptionYes1 associated transcriptional regulator
- Target synonymsCOB1, YAP, YAP-1, YAP2, YAP65, YKI, transcriptional coactivator YAP1, 65 kDa Yes-associated protein, Yes associated protein 1, protein yorkie homolog, yes-associated protein 2, yes-associated protein YAP65 homolog, yorkie homolog
- HostRabbit
- IsotypeIgG
- ReactivityBovine, Canine, Chicken, Equine, Human, Mouse, Porcine, Rabbit, Rat
- Storage Instruction-20°C
- UNSPSC12352203